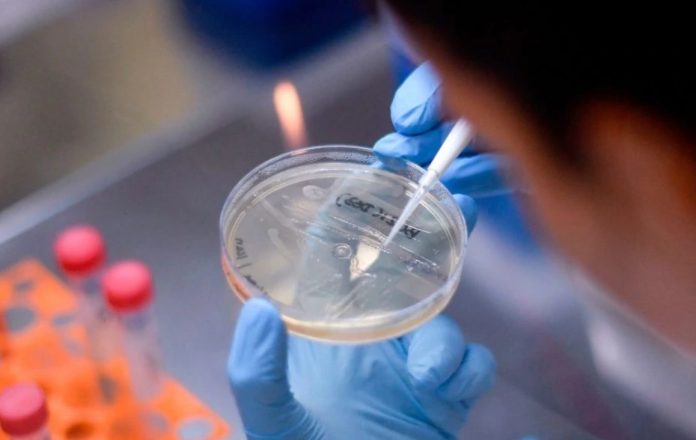

Një gjigant farmaceutik në Britani të Madhe ka zbuluar planet për testimin e një ilaçi të kancerit të gjakut tek pacientët me koronavirus të sëmurë rëndë, pasi tregoi rezultate premtuese në SHBA.
AstraZeneca tha se ka prova anekdotike që medikamenti ‘Kalquence’ për të përmirësuar gjendjen e pacientëve në kujdes intensiv, raporton Daily Mail, transmeton lajmi.net.
Ilaçi për leukemi, e thënë se shtyp virusin dhe parandalon sulmin në mushkëri, tani do të vendoset në një provë të madhe klinike me 400 pacientë.
Calquence iu dha një numri të vogël të pacientëve me COVID-19 në Spitalin e Përgjithshëm Walter Reed në Uashington.
AstraZeneca, me seli në Kembrixh, tha se ‘përfitimi klinik është vërejtur te pacientët e zgjedhur me sëmundje të përparuar të mushkërive’.
COVID-19 mund të vrasë kur nxit një përgjigje imune agresive që infekton dhe sulmon mushkëritë, duke e bërë të vështirë frymëmarrjen.
Duke shtypur mekanizmin e ekzagjeruar të mbrojtjes, medikamenti mund të parandalojë që virusi të dëmtojë mushkëritë.